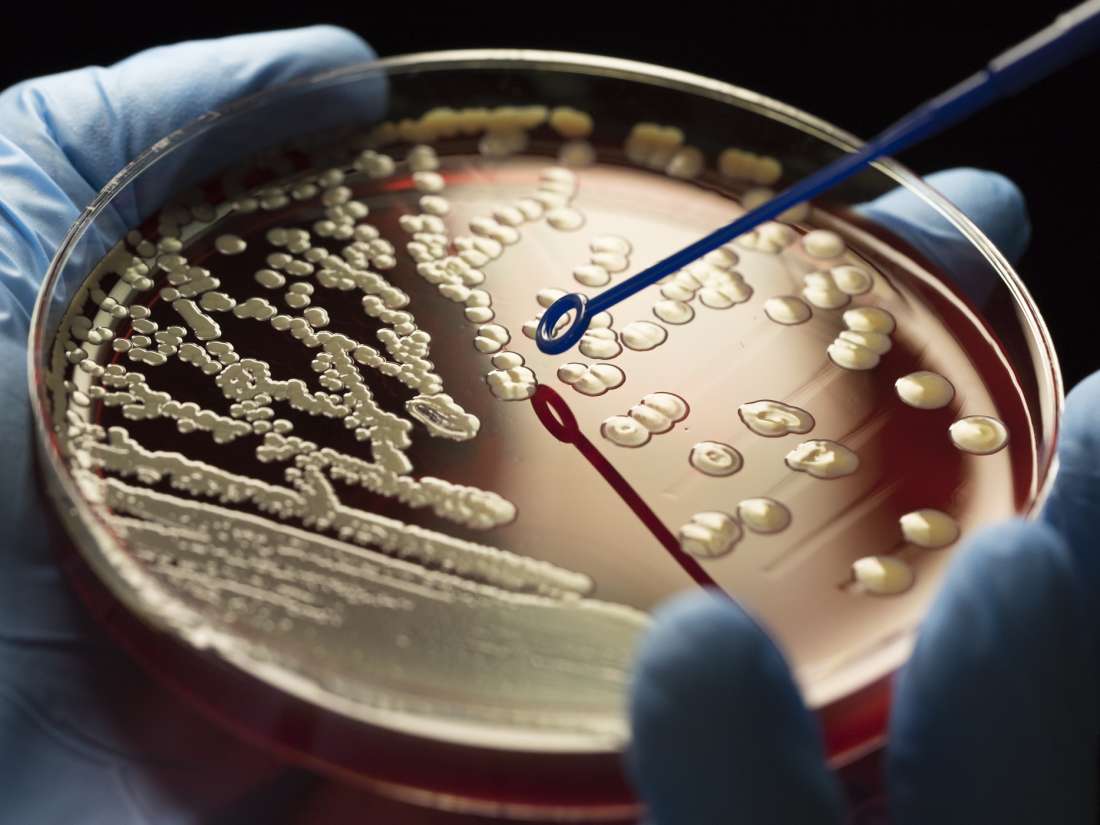
„Ekki einhver dulræn heimsendaspá eða hræðsluáróður – Þetta er raunveruleiki“

Ekki talinn vöxtur í sýklalyfjaónæmi kjúklinga
Vigdís Tryggvadóttir, sérgreinadýralæknir súna og lyfjaónæmis hjá Matvælastofnun, segir villandi að halda því fram að sýnataka í kjúklingum í fyrra, í samræmi við reglugerð um vöktun á sýklalyfjaónæmi í dýrum og matvælum, hafi sýnt vaxandi ónæmi.